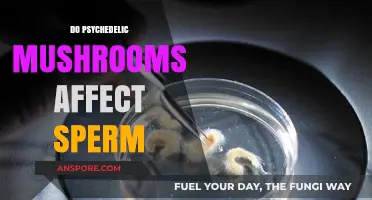
Psychedelic Mushrooms: Impact on Male Fertility?

Magic mushrooms, or psilocybin mushrooms, are known for their psychedelic effects and potential therapeutic benefits for mental health. They are susceptible to spoilage and can expire like any other organic substance. The shelf life of magic mushrooms depends on how they are stored and whether they are fresh or dried. Proper storage is essential to maintain their potency, safety, and longevity. Fresh mushrooms are prone to spoilage due to moisture, light exposure, and temperature fluctuations, and typically have a shorter shelf life than dried mushrooms. Dried mushrooms should be stored in airtight containers or vacuum-sealed bags in a cool, dark, and dry place to minimize exposure to air, moisture, and contaminants. Proper storage techniques can significantly extend the shelf life of magic mushrooms and ensure a safe and rewarding experience.
| Characteristics | Values |
|---|---|
| Shelf life | Magic mushrooms do not expire in the traditional sense but can lose potency and quality over time due to various environmental factors. |
| Storage conditions | Store in a cool, dark, dry place with low humidity, preferably in airtight containers, to preserve their quality and extend shelf life. |
| Factors influencing shelf life | Temperature, moisture, and light exposure can accelerate the degradation of magic mushrooms. |
| Spoilage signs | Discoloration, fuzzy growths, strange colors, bad smell, slippery texture, and unusual odors. |
Explore related products
What You'll Learn
- Fresh mushrooms should be refrigerated and stored in paper bags
- Dried mushrooms should be kept in airtight containers
- Proper storage prevents health risks from consuming spoiled mushrooms
- Mushrooms lose potency over time, even in ideal conditions
- Signs of spoilage include discolouration, unusual textures, and foul smell

Fresh mushrooms should be refrigerated and stored in paper bags
Like any organic substance, magic mushrooms can go bad. They have a short shelf life and are susceptible to contamination and spoilage. Fresh mushrooms, in particular, don't keep for very long. They have a much shorter shelf life compared to dried mushrooms. Fresh mushrooms can spoil within a few days if not properly refrigerated, while dried mushrooms can last for months or even years.
Fresh mushrooms should be refrigerated to slow down decomposition. The refrigerator is the best place to keep them, but which spot you choose impacts preservation. The middle shelf in the fridge is a good option, as it kept mushrooms fresh for up to 10 days in one test. However, it's important to use them within a week of purchase, as they can start to spoil after five days.
To maintain the quality of fresh mushrooms and prevent spoilage, it's crucial to store them in breathable packaging like a paper bag. Paper bags allow airflow and prevent moisture buildup, which leads to quicker spoilage. They absorb the moisture released by mushrooms as they age, keeping the mushroom's surface slime-free. This is especially important because mushrooms are made of 80 to 90 percent water.
It's best to avoid using plastic bags, as they trap humidity and accelerate decay. Plastic wrap can also trap moisture and speed up spoilage. If you don't have a paper bag, you can wrap the mushrooms in a paper towel and place them in a bowl in the refrigerator. The paper towel will absorb moisture, helping the mushrooms stay fresh.
The Ultimate Guide to Storing Mushrooms, by Microbiologists
You may want to see also

Dried mushrooms should be kept in airtight containers
Like any organic material, magic mushrooms are prone to decomposition over time, especially if they are not stored properly. Fresh mushrooms have a much shorter shelf life compared to dried ones. Fresh mushrooms can spoil within a few days if not properly refrigerated, while dried and stored mushrooms can last for months or even years.
Dried mushrooms should also be kept in a cool, dark, and dry environment. Keeping them in cool places ensures better long-term usability and a consistent psychedelic experience. Avoiding high-humidity areas prevents mold growth, which can spoil mushrooms quickly.
It is also important to recognize the signs of spoilage. Mold can appear as small white or green patches. These are clear signs that the mushrooms have gone bad. Look for discoloration, mold growth, or unusual textures in mushroom-infused products. Discoloration to blue due to bruising is normal; other color changes aren't. A foul smell is another clear sign that mushrooms have spoiled.
Mushroom Consumption: Understanding the After Effects
You may want to see also

Proper storage prevents health risks from consuming spoiled mushrooms
Like any organic material, magic mushrooms are susceptible to decomposition and spoilage over time, especially if they are not stored properly. Consuming spoiled mushrooms can lead to a variety of health risks, including gastrointestinal issues such as nausea, vomiting, and diarrhea. Therefore, it is crucial to follow proper storage techniques to prevent health risks associated with consuming spoiled mushrooms.
Fresh mushrooms have a much shorter shelf life compared to dried ones. Fresh mushrooms can spoil within a few days if not properly refrigerated, while dried and stored mushrooms can last for months or even years. When storing fresh mushrooms, it is important to use breathable packaging like a paper bag to allow airflow and prevent moisture buildup, which can lead to spoilage. Plastic bags should be avoided as they trap humidity and accelerate decay. Refrigeration can also help slow down the decomposition of fresh mushrooms.
For dried mushrooms, it is recommended to use airtight containers or vacuum-sealed bags to minimize exposure to air and moisture. Dried mushrooms should be stored in a cool, dark, and dry environment, such as a cupboard or pantry. Avoiding high-humidity areas is crucial to prevent mold growth, which can spoil mushrooms quickly.
By following these proper storage techniques, you can significantly extend the quality and effects of your mushrooms while also preventing potential health risks associated with consuming spoiled mushrooms. It is important to regularly inspect your mushrooms for any signs of spoilage, such as discoloration, mold growth, unusual textures, or unpleasant odors. If you are ever unsure about the quality of your mushrooms, it is always better to err on the side of caution and avoid consuming them.
Mushrooms: Society's Transformative Fungal Force
You may want to see also
Explore related products

Mushrooms lose potency over time, even in ideal conditions
Like any organic material, magic mushrooms are prone to decomposition over time, even in ideal conditions. They do not expire in the traditional sense, but their potency and quality degrade over time. The chemical responsible for their psychedelic effects, tryptamine, decreases over time, even when stored properly.
To preserve their quality and extend their shelf life, it is important to store them in a cool, dark place with low humidity. High temperatures, excess moisture, and light exposure can accelerate the degradation of shrooms, making proper storage crucial. Fresh mushrooms are best stored in breathable packaging like a paper bag to prevent moisture buildup, which can lead to spoilage. They should be refrigerated, which slows down decomposition, and will typically last between five and seven days.
Dried mushrooms should be stored in airtight containers to minimize exposure to air and moisture. They can be kept in a cupboard or pantry, and will last for months or even years. Drying mushrooms is a smart move if you want them to last longer. They don't spoil as quickly, but they still need to be stored properly to prevent spoilage and maintain potency.
To maximize the shelf life of magic mushrooms and ensure their safety for consumption, it is crucial to follow the best practices for storage. It is also important to regularly inspect your mushrooms for any signs of spoilage, such as discoloration, fuzzy growths, or strange colours, which may indicate the presence of mould. If you're ever unsure about the quality of your mushrooms, it's better to err on the side of caution and avoid using them.
Mellow Mushroom Delivery in Savannah: What You Need to Know
You may want to see also

Signs of spoilage include discolouration, unusual textures, and foul smell
Like any organic material, magic mushrooms are susceptible to spoilage and decomposition over time, especially if they are not stored properly. Fresh mushrooms are prone to discolouration, mould, and a slimy texture, all of which are signs of spoilage.
When inspecting for spoilage, look for discolouration, such as dark spots or a dull appearance. Normal discolouration due to bruising may appear blue, but other colour changes are a sign of spoilage. For mushroom-infused chocolates or honey, look for colour or texture changes.
Unusual textures are another sign of spoilage. Fresh mushrooms may develop a slimy or slippery texture, while dried mushrooms may become dry and brittle.
Foul smell is a clear indicator of spoilage. Unusual odours, like a musty or sour scent, signal degradation. If your mushrooms emit a strong, unpleasant odour, they have likely spoiled.
To prevent spoilage, proper storage is essential. Fresh mushrooms should be refrigerated and stored in breathable packaging like a paper bag to prevent moisture buildup. Dried mushrooms should be stored in airtight containers or vacuum-sealed bags in a cool, dark, and dry place to minimise exposure to air, light, and moisture.
Mushroom Production: A Step-by-Step Guide
You may want to see also
Frequently asked questions
Yes, like any organic material, they are prone to decomposition over time, especially if they are not stored properly.
Fresh mushrooms can last up to a week in the refrigerator if stored properly. Dried mushrooms can last for months or even years.
Fresh mushrooms should be stored in a breathable paper bag in the refrigerator to prevent moisture buildup. Dried mushrooms should be stored in airtight containers or vacuum-sealed bags in a cool, dark, and dry place.
Signs of spoilage include discoloration, fuzzy or strange-coloured spots, mould, a bad smell, or a slippery texture.
Consuming spoiled mushrooms can lead to health risks such as gastrointestinal issues like nausea, vomiting, and diarrhoea. It can also lead to a "bad trip", where the desired psychedelic effects are not as strong, resulting in an uncomfortable or unsettling experience.